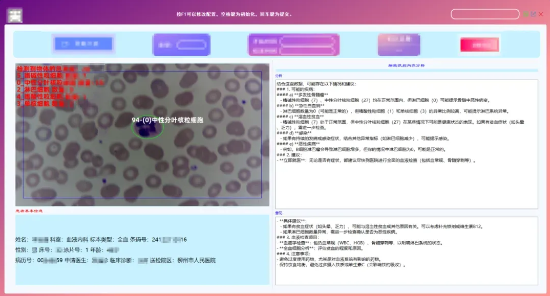
image.png

当前位置: 健康中国> >
柳人医实现DeepSeek本地化部署并启动探索性应用
发布时间: 2025-03-11 15:52:33 | 来源: 中国网健康 | 责任编辑: 曹洋
近日,柳州市人民医院完成DeepSeek人工智能大模型本地化部署,并计划首先在血液内科、医学检验科等科室开展探索性研究应用。当前,医院正朝着“AI+医疗”深度融合的新阶段迈进,通过人工智能技术提升临床诊疗、科研分析与运营管理的效率与精度。作为国产领先的AI大模型,DeepSeek凭借其核心技术特性和开源生态优势成为柳人医智能化转型的关键引擎。医院信息中心主任刘文表示,选择DeepSeek的原因在于其强大的本地化部署能力和严格的数据安全保障机制,能够实现对复杂医学场景的精准匹配,特别是在细胞识别和病理数据分析方面表现突出。目前,由医院自主研发的基于DeepSeek的细胞识别分析系统已初具雏形,预计于2025年3月中旬进行测试上线使用。

DeepSeek本地化部署
在医学检验科,大模型的应用有望优化传统的血常规检测流程。通过深度学习技术,系统能够自动完成血液显微图像处理及细胞分类计数,提高准确率。如在血液系统疾病的诊断中,该系统可以快速识别病变细胞并生成量化报告,辅助医生制定治疗策略。此方案集成了YOLO目标检测算法,实现了从实时处理到智能分析的全链条自动化。血液内科则依托DeepSeek的数据挖掘能力,可以整合患者信息,为血液系统疾病提供个性化诊疗建议。
基于DeepSeek的细胞识别分析系统雏形
DeepSeek落地是柳州市人民医院信息化建设的重要节点,也体现了AI技术在医疗领域的普惠价值。医院将逐步推广AI技术至更多医疗应用场景,推动科研创新和管理革新,以新质生产力促进医院高质量发展,为患者提供更智慧、高效、精准的医疗服务。(柳州市人民医院供稿)
延伸阅读
